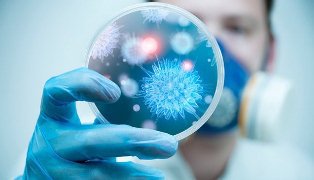

«По всіх областях і районах. План дій у нас був затверджений. У нас буде планова вакцинація, як і повинно бути, і, звичайно, буде вакцинація тих, які не вакцинувалися раніше, щоб попередити поширення вірусу поліомієліту. Цей план був розроблений разом з експертами Всесвітньої організації охорони здоров’я, ЮНІСЕФ і нашими інфекціоністами», - зазначив Міністр.
За його словами, сьогодні в Україну завезено 3 мільйони 700 тисяч доз вакцин. «Останні приїхали в п’ятницю - 2 млн. 200 тис. Це повністю покриває ту потребу, яка буде в цьому році. І, наск ільки я розумію, наступні 6 місяців 2016 року», - повідомив Олександр Квіташвілі.
При цьому він зазначив, що оскільки в Україні вакцинація від поліомієліту, і по іншим напрямкам, за останні кілька років була провалена, доведеться перевакціновувати тих, хто не робив цього раніше. І тому потрібна буде ще додаткова кількість доз. «Потрібна, але не відразу. Тому ми працюємо з ЄС, вони вже запропонували свою допомогу, щоб перекрити на 100% і пропущені вакцинації, і наступні».
Крім цього, Міністр повідомив, що вже сьогодні планується підписання Меморандуму з ЮНІСЕФ щодо купівлі медпрепаратів через міжнародні організації.
«З ЮНІСЕФ меморандум уже готовий і я, напевно, сьогодні буду його підписувати. Решта теж будуть готові цього тижня. Це означає, що близько 2,5 млрд. грн. до держбюджету будуть направлятися через міжнародні організації. Перелік препаратів, на які вони направлені, вже затверджено. І це хороша новина та перший крок переходу України на закупівлю препаратів через міжнародні організації», - наголосив він.
Про це повідомляє прес-служба РОДА.










